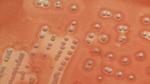
ما هو تسمم الدم

ما هو تسمم الدم
تسمم الدمتسمم الدم أو الإنتان أو خمج الدم هو عبارة عن حالة مرضية خطيرة تُصيب الإنسان والحيوان، وتتميز بتفاعلها الالتهابي بسبب التعرض لعدوى جرثومية أو ظهور
تسمم الدم
تسمم الدم أو الإنتان أو خمج الدم هو عبارة عن حالة مرضية خطيرة تُصيب الإنسان والحيوان، وتتميز بتفاعلها الالتهابي بسبب التعرض لعدوى جرثومية أو ظهور الجراثيم في الدم والأنسجة، حيث تنتشر حاملات المرض إلى الدم ثمَّ إلى الأعضاء الداخلية للجسم، وعلى الرغم من أنّ نظام المناعة لدى الإنسان كفيل بالدفاع عنه ضد الالتهابات الجرثومية، إلا أنَّ هذا النوع من الجراثيم يُضعف جهاز المناعة لدى الإنسان ويُسبب له الأذى والضرر.
أسباب تسمم الدم
تسمم الدم من الظواهر الشائعة التي يُصاب بها عدد كبير من الناس مثل الأشخاص المصابين بالسرطان، أو مرضى الإيدز، أو مرضى استئصال الطحال، والذين يخضعون إلى علاج كيميائي، وإصابات الجهاز المناعي، وبشكلٍ عام يُصاب الإنسان بتسمم الدم نتيجة نوع من البكتيريا حيث تكون العدوى داخلية في الجلد، ويُصاب الإنسان بتسمم الدم نتيجة أعراض خارجية يُصاب بها المتعاطون بجرعات مخدرة عن طريق الحقن، وتنتج نتيجة الإصابة بالحروق من الدرجات العالية.
أعراض تسمم الدم
يُعتبر مرض تسمم الدم من الأمراض الخطيرة جداً؛ لأنّ الدراسات والأبحاث الحديثة بيَّنت أنّ أعراض المرض في المراحل الأولى تُشبه إلى حدٍ كبير أعراض الزكام، مما يؤدي ذلك إلى هدوء المصاب وعدم توقع الخطورة العائدة عليه من المرض، ويفترض أنّه مرض مؤقت ولا يحتاج إلى طبيب، ويكتفي ببعض المسكنات أو المضادات العادية، وهذا بحد ذاته يُسبب خطر كبير على حياة المُصاب؛ لأنّه في بداية الأمر يشعر بالكسل والخمول، والغثيان، والارتباك، وفرط التهوية، والتقيؤ والتعب، والضعف العام، وتتحول هذه الأعراض حتى يُصاب الإنسان بالحمى الشديدة مع القشعريرة، وزيادة في ضربات القلب، وصعوبة في التنفس والدوخة، وهبوط في ضغط الدم.
تشخيص تسمم الدم
يشخص الخبراء والأطباء تسمم الدم بعمل فحص زراعة الدم مع تناول نوع معين من المضادات الحيوية، أي أنّه بشكلٍ أساسي يُعالج بالمضادات الحيوية حيث يبدأ الطبيب بتوقع مصدر العدوى من المسالك البولية، أو كيس المرارة، أو الرئتين، وبعد أخذ نتيجة اختبار تحسس الجراثيم بالمضاد الحيوي يبدأ الطبيب بعمل فحوصات سريرية لفحص مدى استجابة المريض للعلاج، ويتم التفكير في عمل جراحة بهدف إزالة كتل الجراثيم من الدم، وبشكلٍ عام يُساعد التدخل الطبي المبكر على علاج العدوى البكتيرية ويحد من مضاعفاتها.
تسمم الدم الوليدي
الإنتان الوليدي أو تسمم الدم الوليدي هو نوع من تعفن دم الإنسان، ويُشير بشكل محدد إلى وجود عدوى بكتيرية في الدم مثل التهاب السحايا، والالتهاب الرئوي، والتهاب الحويضة والكلية، أو التهاب الأمعاء والمعدة عند الإصابة بالحمى، ويوشك الأطفال حديثي الولادة على الموت عند إصابتهم بتسمم الدم الوليدي، لأنّه ليس من السهل تنبؤ أعراض المرض عليهم.
فيديو التهاب الدم وأسبابه
شاهد الفيديو لتعرف عن التهاب الدم وأسبابه :
المقال السابق: ما هو الفقه الاسلامي
المقال التالي: طرق تنحيف البطن
ما هو تسمم الدم: رأيكم يهمنا

0.0 / 5
0 تقييم
